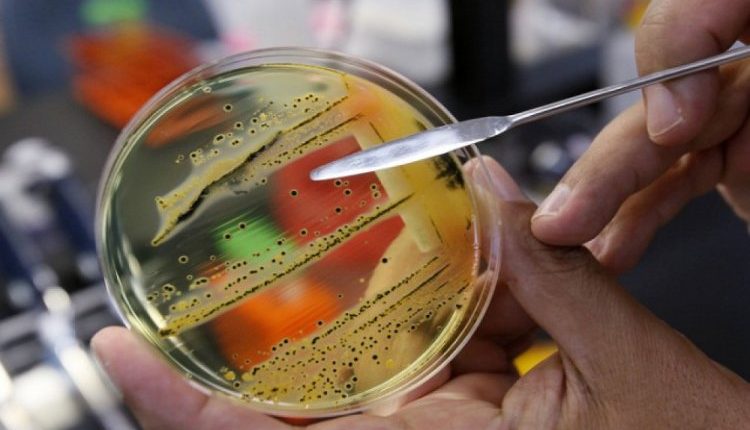

В Харьковской области ищут опасные продукты питания, которые заражены сальмонеллой. Об этом сообщили в региональном управлении Госпродпотребслужбы.
Больная бешенством кошка укусила женщину, пытавшуюся ее лечить
Согласно данным Европейской системы быстрого оповещения о продуктах и кормах, в Украину, Латвию и ряд стран-членов ЕС экспортировали замороженное мясо птицы из Польши. Его производителем стало предприятие CEDROB S.A. Однако в ходе проверок выяснилось, что в продукте находятся возбудители сальмонеллеза. В нашей стране опасную продукцию получили компании SPE “Winter” (Луцк), “Вик Логистик” (Черкассы) и “Европостач” (Киев).
Управлении Госпродпотребслужбы обращается к операторам рынков в Харьковской области с просьбой изъять из оборота мясо, полученное от данных экспортеров, и в течение двух дней оповестить об этом.
В Харьковской области женщину сняли с поезда из-за резкого ухудшения здоровья
Напомним, ранее на таможенном посту “Харьков-Центральный” контролеры не пропустили груз импортных продуктов из Ирана. 17 апреля во время проверки 20-тонной партии фиников выяснилось, что у владельцев отсутствует фитосанитарный сертификат, подтверждающий безопасность продукта. В связи с этим груз задержали, а в страну-импортера направили нотификацию о нарушении.

Комментарии